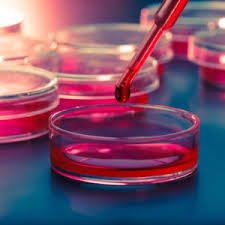

₹720

We Uses Cookies
This website uses cookies to enhance
your browsing experience.

We Uses Cookies
This website uses cookies to enhance
your browsing experience.

BLOOD CULTURE & SENSITIVITY
₹720
₹900
20% off
Share this product
Just one more step!
Login first,to proceed further.